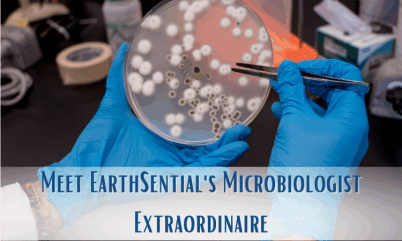
meet earthSential’s microbiologist extraordinaire

Natural Pet Cleaning Products
Safe, Delicate, and Pure Cleaning Solutions
Keep your pets’ spaces spotless and safe without harsh chemicals

with EarthSential All Natural Pet Products

Our All Natural Pet Cleaners
Safety First
Trusted Formulations
Nature’s Bounty
Effective Results
Cruelty-Free
FAQ’s
Are EarthSential’s all natural pet products environmentally friendly?
- Absolutely! EarthSential is committed to sustainability and uses environmentally responsible ingredients and packaging in all our pet products.
Are EarthSential’s all natural pet products cruelty-free?
- Yes, EarthSential is proud to be a cruelty-free brand. Our products are never tested on animals.
Can I use EarthSential’s pet odor eliminator spray on furniture and fabrics?
- Yes, our pet odor eliminator spray is safe to use on a variety of surfaces, including furniture and fabrics. Just spray directly on the affected area and let it air dry.
Can I use EarthSential’s pet toy cleaner on all types of pet toys?
- Yes, our pet toy cleaner is suitable for use on a variety of pet toys, including plastic, metal, wood, and fabric toys.
Do EarthSential’s pet products contain any harmful chemicals?
- No, our pet products are made from 100% natural ingredients and do not contain any harmful chemicals, ensuring the safety and well-being of your pet.
Related Stories
meet earthSential’s microbiologist extraordinaire
Bacteria-Busting Brilliance The Microbiologist at EarthSential In the realm of cleaning products, it's not often that you come across a microbiologist wielding the tools of their trade to craft effective solutions. However, EarthSential, the brand committed to safer...